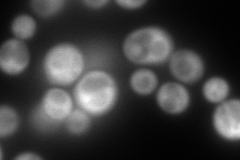
YJL153C
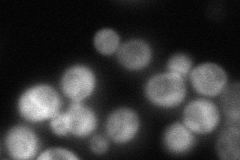
YJL153C
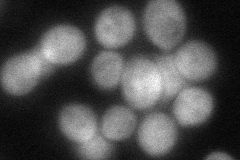
YJL153C
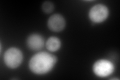
YJL153C
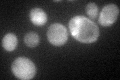
YJL153C

View description
Inositol 1-phosphate synthase, involved in synthesis of inositol phosphates and inositol-containing phospholipids; transcription is coregulated with other phospholipid biosynthetic genes by Ino2p and Ino4p, which bind the UASINO DNA element
Localization:
Intensity:
Fold change:
Significance:
-
C’ GFP library in SD

cytosol288.75 -
N' NOP1pr-GFP in SD

cytosol329.877 -
N' TEF2pr-mCherry in SD
cytosol329.246 -
N' NATIVEpr-GFP in SD
cytosol78.3761 -
N' TEF2pr-VC and Cyto-VN in SD
cytosol85.0781 -
C’ GFP library in SD+DTT
cytosol565.361.95Yes -
C’ GFP library in SD+H2O2

cytosol174.970.6No -
C’ GFP library in Starvation Media
cytosol69.370.24Yes -
C’ GFP library on the background of Pup2-DaMP

cytosol -
C’ GFP library on the background of CCT mutant

cytosol207.2030.71756Yes
